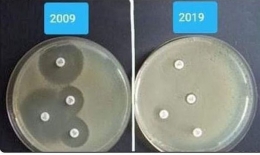
“Thử thách 10 năm” cho thấy vi khuẩn đã không còn đáp ứng với thuốc như trước

4 thực phẩm hỗ trợ phòng ngừa ung thư được...
Trà xanh, cá biển, nấm agaricus, rong nâu được người Nhật sử dụng phổ biến trong bữa ăn để phòng...
Ai cũng có tế bào ung thư trong cơ thể:...
Tế bào ung thư luôn tiềm tàng trong cơ thể mỗi chúng ta nhưng nó được kiểm soát bởi một...
Những triệu chứng rất phổ biến có thể là dấu...
Ung thư dạ dày không phải là bệnh phổ biến. Khả năng một người phụ nữ mắc phải căn bệnh...
“Thử thách 10 năm” cho thấy vi khuẩn đã không...
So với bức ảnh “thử thách 10 năm” 2009, kháng sinh có vẻ không được tốt lắm.
30 vấn đề sức khỏe mà phụ nữ tuổi 40...
Phụ nữ ngày nay không còn sợ tuổi trung niên và cảm thấy khỏe mạnh hơn bao giờ hết, nhờ...
Làm thế nào để bỏ thuốc lá trong năm 2019?
Mỗi năm hút thuốc lá gây ra nhiều ca tử vong hơn cả HIV, ma túy, rượu, tai nạn giao...
Ăn gì để ấm trong mùa lạnh?
Mùa Đông về thời tiết trở lạnh khiến chúng ta dễ bị cảm lạnh và cúm. Để có thể phòng...
20 dấu hiệu cảnh báo từ gan bạn cần biết
Gan phải đảm nhiệm rất nhiều công việc để phục vụ cho sức khỏe. Là một trong những cơ quan...
Danh mục sản phẩm
Y tế - Sức khỏe
Tin tức công ty
Tin tức hoạt động
 HÂN HOAN CHÀO MỪNG: CUỘC HỌP TỔNG KẾT HOẠT ĐỘNG KINH DOANH NĂM 2018 & CHIẾN LƯỢC PHÁT TRIỂN NĂM 2019
HÂN HOAN CHÀO MỪNG: CUỘC HỌP TỔNG KẾT HOẠT ĐỘNG KINH DOANH NĂM 2018 & CHIẾN LƯỢC PHÁT TRIỂN NĂM 2019
19/12/2018
 TỔNG KẾT HOẠT ĐỘNG KINH DOANH NĂM 2018 & CHIẾN LƯỢC PHÁT TRIỂN NĂM 2019 (khu vực phía Nam)
TỔNG KẾT HOẠT ĐỘNG KINH DOANH NĂM 2018 & CHIẾN LƯỢC PHÁT TRIỂN NĂM 2019 (khu vực phía Nam)
19/12/2018
 Nhà máy Dolexphar – Đơn vị thành viên của Đại Sơn Group vinh dự đạt chứng nhận GMP của Bộ Y tế
Nhà máy Dolexphar – Đơn vị thành viên của Đại Sơn Group vinh dự đạt chứng nhận GMP của Bộ Y tế
19/12/2018
 Đơn vị sản xuất của Đại Sơn Group đón nhận danh hiệu top 10 nhà máy đạt tiêu chuẩn GMP - Thực phẩm bảo vệ Sức khỏe
Đơn vị sản xuất của Đại Sơn Group đón nhận danh hiệu top 10 nhà máy đạt tiêu chuẩn GMP - Thực phẩm bảo vệ Sức khỏe
19/12/2018
 ĐẠI SƠN GROUP - TOP 10 SẢN PHẨM CHẤT LƯỢNG VÌ SỨC KHOẺ CỘNG ĐỒNG, TOP 10 DOANH NGHIỆP UY TÍN - THƯƠNG HIỆU HỘI NHẬP 4.0
ĐẠI SƠN GROUP - TOP 10 SẢN PHẨM CHẤT LƯỢNG VÌ SỨC KHOẺ CỘNG ĐỒNG, TOP 10 DOANH NGHIỆP UY TÍN - THƯƠNG HIỆU HỘI NHẬP 4.0
19/12/2018
 Cuộc thi ảnh online: BLOUSE TRẮNG - SÁNG NGỜI TÂM ĐỨC (lần thứ 1) chào mừng ngày thầy thuốc Việt Nam 27/2
Cuộc thi ảnh online: BLOUSE TRẮNG - SÁNG NGỜI TÂM ĐỨC (lần thứ 1) chào mừng ngày thầy thuốc Việt Nam 27/2
19/12/2018
 Nhân viên GPS Group cover vũ điệu rửa tay Ghen Cô Vy – tuyên truyền ý thức chống dịch Covid-19
Nhân viên GPS Group cover vũ điệu rửa tay Ghen Cô Vy – tuyên truyền ý thức chống dịch Covid-19
19/12/2018
 ĐẠI SƠN GROUP: PHÁT ĐỘNG QUYÊN GÓP ỦNG HỘ CHƯƠNG TRÌNH THIỆN NGUYỆN NGHĨA TÌNH MÙA DỊCH MÙA 2
ĐẠI SƠN GROUP: PHÁT ĐỘNG QUYÊN GÓP ỦNG HỘ CHƯƠNG TRÌNH THIỆN NGUYỆN NGHĨA TÌNH MÙA DỊCH MÙA 2
19/12/2018
 ĐẠI SƠN GROUP: LỜI TRI ÂN NHỮNG TẤM LÒNG NHÂN ÁI THAM GIA ỦNG HỘ CHO CHƯƠNG TRÌNH NGHĨA TÌNH MÙA DỊCH - ĐỢT 2
ĐẠI SƠN GROUP: LỜI TRI ÂN NHỮNG TẤM LÒNG NHÂN ÁI THAM GIA ỦNG HỘ CHO CHƯƠNG TRÌNH NGHĨA TÌNH MÙA DỊCH - ĐỢT 2
19/12/2018
19/12/2018
 [TỔNG HỢP] DANH SÁCH KHÁCH HÀNG ĐẠT GIẢI CHƯƠNG TRÌNH “16 NĂM ĐỒNG HÀNH – TRI ÂN NGÀN QUÀ TẶNG”
[TỔNG HỢP] DANH SÁCH KHÁCH HÀNG ĐẠT GIẢI CHƯƠNG TRÌNH “16 NĂM ĐỒNG HÀNH – TRI ÂN NGÀN QUÀ TẶNG”
19/12/2018
 GPS GROUP HỌP SƠ KẾT HOẠT ĐỘNG 6 THÁNG ĐẦU NĂM, ĐỊNH HƯỚNG CHIẾN LƯỢC PHÁT TRIỂN 6 THÁNG CUỐI NĂM 2023
GPS GROUP HỌP SƠ KẾT HOẠT ĐỘNG 6 THÁNG ĐẦU NĂM, ĐỊNH HƯỚNG CHIẾN LƯỢC PHÁT TRIỂN 6 THÁNG CUỐI NĂM 2023
19/12/2018
 ĐẠI SƠN GROUP TỰ HÀO ĐÓN NHẬN GIẢI THƯỞNG “TOP 10 - SẢN PHẨM CHẤT LƯỢNG & DỊCH VỤ UY TÍN NĂM 2023”
ĐẠI SƠN GROUP TỰ HÀO ĐÓN NHẬN GIẢI THƯỞNG “TOP 10 - SẢN PHẨM CHẤT LƯỢNG & DỊCH VỤ UY TÍN NĂM 2023”
19/12/2018
 ĐẠI SƠN GROUP VÀ WORLDPHAR TỔ CHỨC THÀNH CÔNG CHƯƠNG TRÌNH LIVESTREAM: “VUI HÈ RỘN RÀNG – TRIỆU QUÀ TRI ÂN”: XẾ SANG ĐÃ CÓ CHỦ
ĐẠI SƠN GROUP VÀ WORLDPHAR TỔ CHỨC THÀNH CÔNG CHƯƠNG TRÌNH LIVESTREAM: “VUI HÈ RỘN RÀNG – TRIỆU QUÀ TRI ÂN”: XẾ SANG ĐÃ CÓ CHỦ
19/12/2018
 LIVESTREAM QUAY SỐ “TRÚNG XE LỘC VÀNG – NGẬP TRÀN QUÀ TẶNG”: TỔ CHỨC THÀNH CÔNG – THÔNG TIN MINH BẠCH
LIVESTREAM QUAY SỐ “TRÚNG XE LỘC VÀNG – NGẬP TRÀN QUÀ TẶNG”: TỔ CHỨC THÀNH CÔNG – THÔNG TIN MINH BẠCH
19/12/2018
 GPS GROUP TỔ CHỨC THÀNH CÔNG TỔNG KẾT HOẠT ĐỘNG KINH DOANH NĂM 2023 & MỤC TIÊU PHÁT TRIỂN NĂM 2024
GPS GROUP TỔ CHỨC THÀNH CÔNG TỔNG KẾT HOẠT ĐỘNG KINH DOANH NĂM 2023 & MỤC TIÊU PHÁT TRIỂN NĂM 2024
19/12/2018
 ĐẠI SƠN GROUP CHÀO ĐÓN ĐOÀN SINH VIÊN KHOA DƯỢC TRƯỜNG ĐẠI HỌC DUY TÂN ĐẾN THAM QUAN VÀ HỌC TẬP
ĐẠI SƠN GROUP CHÀO ĐÓN ĐOÀN SINH VIÊN KHOA DƯỢC TRƯỜNG ĐẠI HỌC DUY TÂN ĐẾN THAM QUAN VÀ HỌC TẬP
19/12/2018
 HỌP THƯỜNG NIÊN SƠ KẾT HOẠT ĐỘNG 6 THÁNG ĐẦU NĂM & CHIẾN LƯỢC PHÁT TRIỂN 6 THÁNG CUỐI NĂM 2024
HỌP THƯỜNG NIÊN SƠ KẾT HOẠT ĐỘNG 6 THÁNG ĐẦU NĂM & CHIẾN LƯỢC PHÁT TRIỂN 6 THÁNG CUỐI NĂM 2024
19/12/2018
 ĐẠT CHỨNG NHẬN FDA – ĐẠI SƠN GROUP KHẲNG ĐỊNH VỊ THẾ THƯƠNG HIỆU CHĂM SÓC SỨC KHỎE HÀNG ĐẦU
ĐẠT CHỨNG NHẬN FDA – ĐẠI SƠN GROUP KHẲNG ĐỊNH VỊ THẾ THƯƠNG HIỆU CHĂM SÓC SỨC KHỎE HÀNG ĐẦU
19/12/2018
 GIẢI THƯỞNG THE BEST OF VIETNAM 2024 (THƯƠNG HIỆU – SẢN PHẨM – DỊCH VỤ TỐT NHẤT VIỆT NAM 2024) GỌI TÊN ĐẠI SƠN GROUP
GIẢI THƯỞNG THE BEST OF VIETNAM 2024 (THƯƠNG HIỆU – SẢN PHẨM – DỊCH VỤ TỐT NHẤT VIỆT NAM 2024) GỌI TÊN ĐẠI SƠN GROUP
19/12/2018
 ĐẠI SƠN GROUP TỔ CHỨC THÀNH CÔNG TỔNG KẾT HOẠT ĐỘNG KINH DOANH NĂM 2024 & MỤC TIÊU HOẠT ĐỘNG NĂM 2025
ĐẠI SƠN GROUP TỔ CHỨC THÀNH CÔNG TỔNG KẾT HOẠT ĐỘNG KINH DOANH NĂM 2024 & MỤC TIÊU HOẠT ĐỘNG NĂM 2025
19/12/2018
 ĐẠI SƠN GROUP GHI DẤU ẤN TẠI HỘI NGHỊ KHÁCH HÀNG “ĐỒNG HÀNH PHÁT TRIỂN – VỮNG BƯỚC VƯƠN XA”
ĐẠI SƠN GROUP GHI DẤU ẤN TẠI HỘI NGHỊ KHÁCH HÀNG “ĐỒNG HÀNH PHÁT TRIỂN – VỮNG BƯỚC VƯƠN XA”
19/12/2018
 ĐẠI SƠN GROUP TỔ CHỨC THÀNH CÔNG CUỘC HỌP TỔNG KẾT HOẠT ĐỘNG KINH DOANH NĂM 2025 & CHIẾN LƯỢC PHÁT TRIỂN NĂM 2026
ĐẠI SƠN GROUP TỔ CHỨC THÀNH CÔNG CUỘC HỌP TỔNG KẾT HOẠT ĐỘNG KINH DOANH NĂM 2025 & CHIẾN LƯỢC PHÁT TRIỂN NĂM 2026
19/12/2018
Giải thưởng

Đối tác


Đăng ký nhận thông tin
Khách hàng có thể đăng ký email để nhận được những thông tin mới nhất từ chúng tôi

Nếu vô tình để dao cắt vào ngón tay, mọi người đừng quá sợ hãi, mất bình tĩnh. Hãy thực...